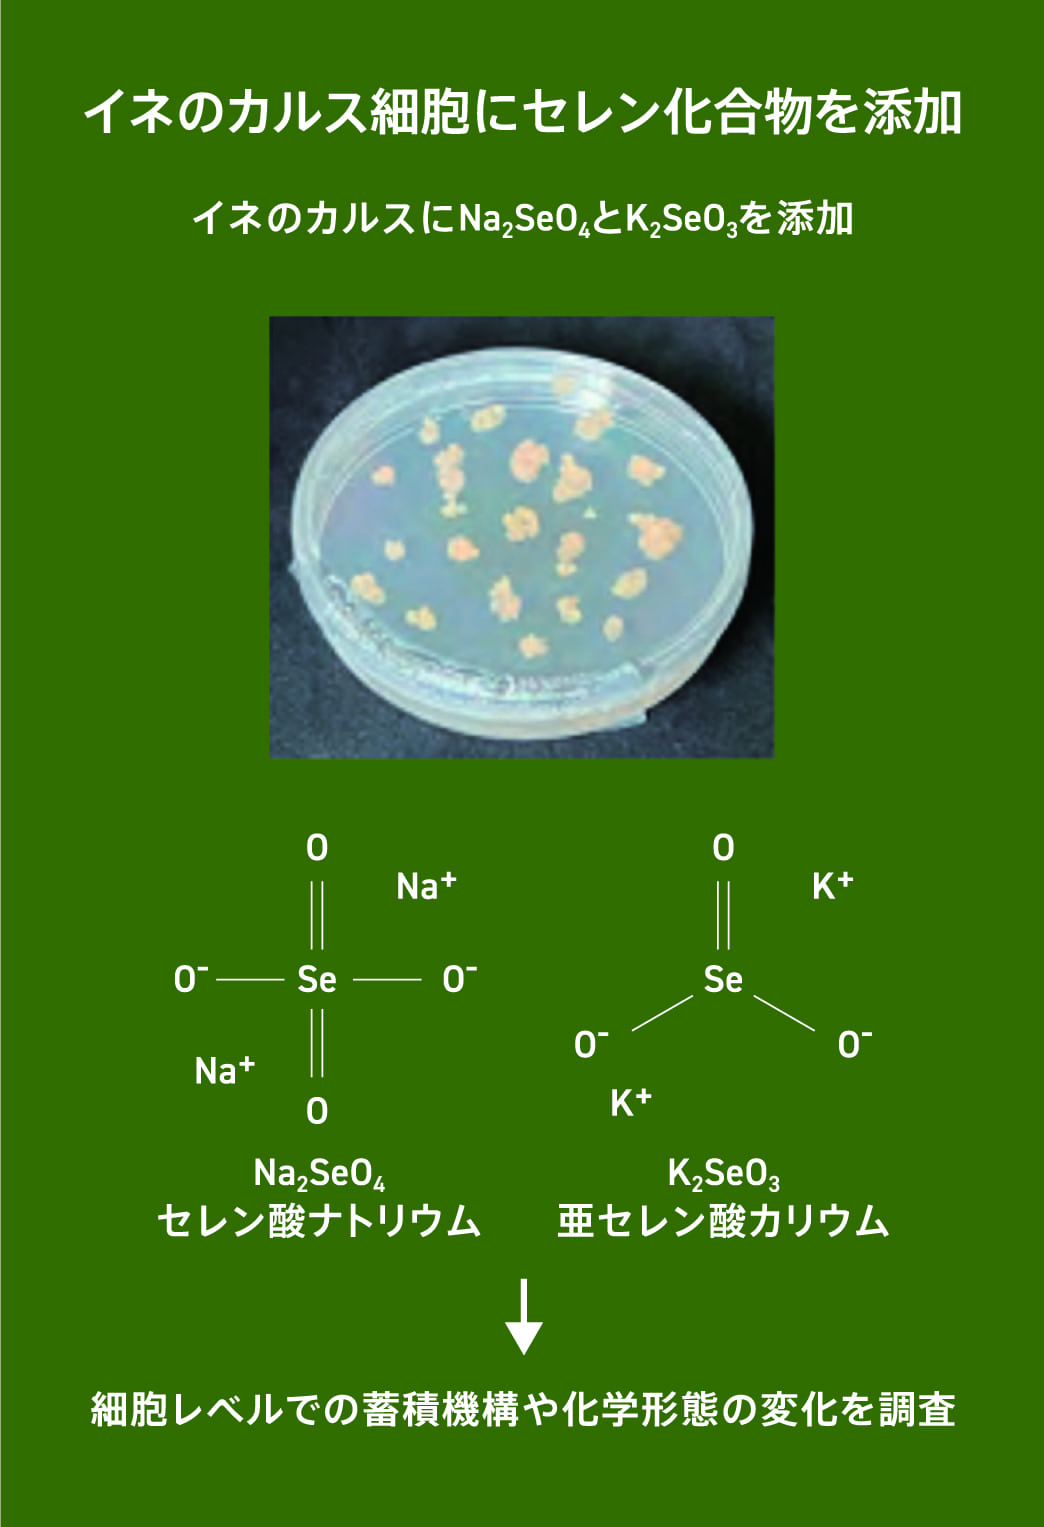
イネのカルスにおけるセレンの化学形態分析のイメージ画像

生物にとって必要な 元素「セレン」に着目 含有率が高い イネの誕生に向け研究中
工学部 応用化学科 4年
埼玉県/春日部共栄高校 出身
大胡 海翔 さん
研究テーマ イネのカルスにおける セレンの化学形態分析
セレンとは、生物にとって必須な微量元素であり、私たちは食品などから摂取しています。しかし、世界には、土壌のセレン濃度が低く、セレンを食品から十分に摂取できない人たちが存在します。問題解決のために、セレンの含有率の高い食品開発が進められています。私は穀物に注目してセレンを含むイネの開発に取り組んでいます。イネは世界の人口の約50%の人々が主食にしていると推定されており、多くの人を助けることができると考えています。開発するためには、まずイネとセレンの関係性を明確にする必要があります。イネによるセレンの取り込みを細胞レベルで調べるために、イネの未分化培養細胞であるカルスを使っています。これまでの研究で、イネのカルス細胞内に取り込まれたセレン化合物は、その化学形態が変化して不溶性のナノ粒子になることが分かってきました。セレンの化学形態変化の詳細やセレンを高蓄積する添加条件などを、さらに明らかにしたいと思っています。この研究を、セレンを多く含むイネの誕生につなげて、世界の健康問題の解決に貢献したいと考えています。
Dig
Dig
誰も見たことのない研究成果を掘り当てたいと思う
新規分野を開拓するような実験を通じて、誰も知らない「何か」を発見することを目指している。さらに自分のテーマを深化させていきたい。
分析化学研究室とは
放射光X線を使って重金属を蓄積する植物を研究している。環境浄化技術に役立ち、また有用な重金属を高濃度に蓄積した植物は、新たな元素資源となる可能性を秘めている。
保倉 明子 教授
